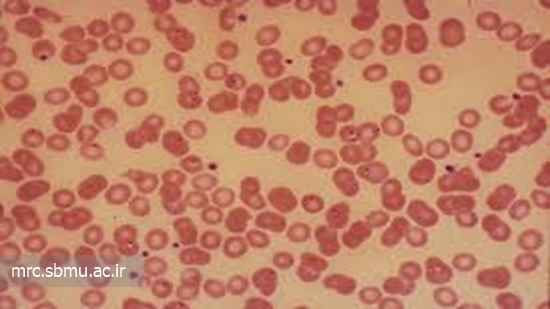

شمار مونوسیت های خون محیطی به تشخیص و شناسایی خطرات سل کمک می نماید
بر اساس اطلاعاتی که به تازگی منتشر گردیده است، ترکیب تست پوستی توبرکولین و شمار مونوسیت های خون محیطی به پزشکان کم می نماید که آن دسته از افرادی که در معرض خطر پیشرفت سل قرار دارند را شناسایی نمایند.
بر اساس اطلاعاتی که به تازگی منتشر گردیده است، ترکیب تست پوستی توبرکولین و شمار مونوسیت های خون محیطی به پزشکان کم می نماید که آن دسته از افرادی که در معرض خطر پیشرفت سل قرار دارند را شناسایی نمایند. این یافته ها، با هدف قرار دادن افرادی که به تازگی در معرض سل قرار گرفته اند، سبب بهبود بخشیدن به استراتژی های موجود برای درمان های پیشگیرانه سل می گردند و به پیشرفت های قابل توجهی در اقدامات جهانی کنترل کننده سل منجر خواهند گردید.
منبع : www.healio.com


نظر